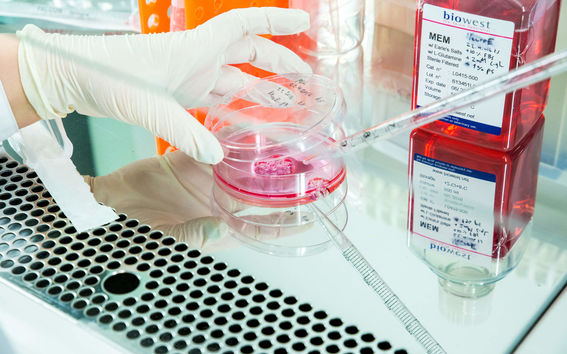
Laboratory work

HR Services - School of Chemical Engineering
Contact details for HR Services in the School of Chemical Engineering
HR Services at the School of Chemical Engineering supports human resources management through offering services to managers and departments as part of the university's HR Services organisation.
HR services personnel at the school and its units are listed below. Local HR will help you with all other personnel matters, except questions related absences, annual leaves, working hours and Workday Support.
Which address do I contact?
Service Address |
Subject |
| hrservices@aalto.fi |
My annual leave My absence, family leave My working time Use of Tiima system Use of Workday system |
| payroll@aalto.fi |
My tax card My taxation My pay slip or pay question |
| sickleaves@aalto.fi | Submit my medical certificate |
| hr-chem@aalto.fi | All other HR matters |






